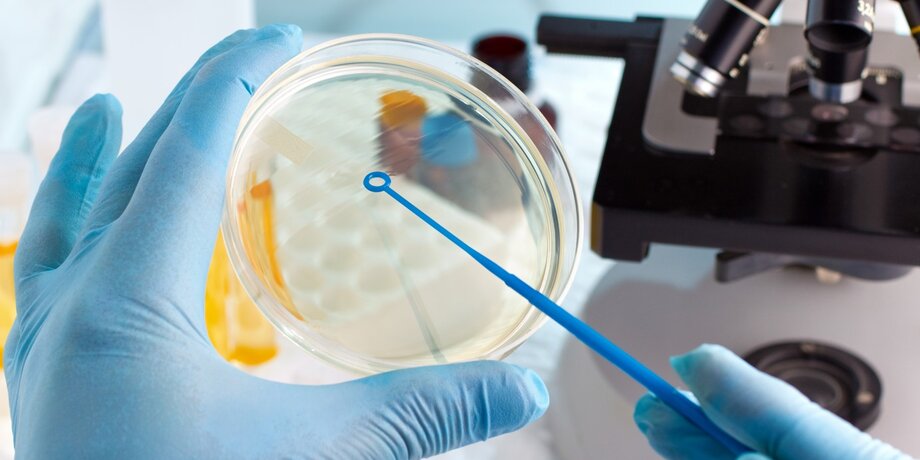

Сколько вирусов нашли в ледниках
За последние несколько столетий человечество сделало несколько огромных шагов вперед – люди изобрели Интернет, научились лечить болезни, которые ранее считались смертельными, создали искусственный интеллект и даже побывали в космосе. Тем не менее, огромное количество природных явлений все еще остается загадкой для человека.
Сегодня весь мир отчаянно борется с коронавирусом, который стремительно распространяется по нашей планете, и подобные эпидемии случаются регулярно – вирус Эбола и Марбурга, вспышки свиного и птичьего гриппа, атипичная пневмония, желтая лихорадка. И в этот список входят только те пандемии, которые случились на Земле за последние десять лет.
И все же, все вышеперечисленные вирусы уже были известны науке, поскольку являлись мутировавшими версиями существующих. Однако наша планета хранит куда более загадочные и пугающие находки, которые могут воскреснуть спустя тысячи и даже миллионы лет сна.
Жизнь в вечной мерзлоте
Еще в 1979 году советский доктор биологических наук Сабит Абызов изучал ледники в Антарктиде и сделал удивительное открытие. В замершем грунте он обнаружил живые микроорганизмы, которым было более 400 тысяч лет. Эта находка вдохновила ученых со всего мира продолжить поиски древних организмов в ледниках – и их исследования вскоре дали свои плоды.
Воскресшие гигантские вирусы
Уже в 2007 году исследователям из Копенгагенского университета удалось выделить ДНК из бактерий, чей возраст достигал примерно полумиллиона лет, а спустя несколько лет ученый из России обнаружил еще более древние микроорганизмы, возрастом около 3,5 миллионов лет. Самой древней находкой стали соляные кристаллы из США с живыми бактериями, которые застали зарождение динозавров на нашей планете.
Найденные микроорганизмы, мимивирусы, пандоравирусы, питовирусы и молливирусы, получили название гигантских вирусов, поскольку их размер составляет около одного микрометра и его даже можно увидеть в обычный оптический микроскоп.
Эти типы вирусов не несут прямой угрозы человечеству, поскольку имеют способность паразитировать лишь на амебах. Однако никто с точностью не может сказать, какие еще микроорганизмы сохранились во льдах вечной мерзлоты, и какое влияние они могут оказать на людей в случае активации, а тот факт, что жизнь в вечной мерзлоте существует, и существует уже на протяжении стольких лет, говорит о том, что наша планета действительно изучена не до конца и хранит массу загадок.
Напрасные опасения или реальная угроза?
В 2016 году группа исследователей обнаружила под землей пещер в Нью-Мексико особый вид бактерий Paenibacillus, которые жили еще четыре миллиона лет тому назад. Проведя ряд исследований, ученые выяснили, что найденные микроорганизмы устойчивы к 70% современных антибиотиков. Это исследование поразило биологов – бактерии, которые провели столько времени в ледяном заточении без возможности размножаться, адаптировались к условиям и смогли выжить, при этом выработав иммунитет к большинству современных лекарств.
А чуть позже, в том же 2016 году, мир столкнулся с реальной эпидемией, начавшейся после таяния льдов. Четыре года назад в Салехарде была зафиксирована вспышка сибирской язвы – это произошло впервые за последние 75 лет, а причиной эпидемии стали микроорганизмы, жившие в замерзших могильниках.
Дело в том, что в период с 1897 по 1925 года на территориях Ямала были захоронены сотни погибших от сибирской язвы оленей, после чего эти захоронения стали частью замерзших территорий. Однако летом 2016 года в Ямало-Ненецком округе были зафиксированы рекордно высокие температуры, и ледники начали таять, освобождая смертоносные бактерии.
В результате эпидемии погибло почти три тысячи оленей, девяносто человек попали в инфекционные больницы и один ребенок скончался.
Этот инцидент обеспокоил исследователей, поскольку во льдах вечной мерзлоты находится масса трупов животных, которые погибали от давно забытых вирусных инфекций, а также старые кладбища и тела тех людей, которые умерли в результате чумы, оспы, холеры и других опаснейших заболеваний прошлого.
Кроме того, все новые и новые открытия исследователей говорят о том, что в толще льда могут находиться и более опасные и разнообразные вирусы, которые способны вызывать целые эпидемии. Открыватель одного из гигантских вирусов Жан-Мишель Клаверье считает, что эти опасения не напрасны – таяние льдов началось еще в 1970 году, и нет оснований полагать, что этот процесс завершится. Одновременно с этим ученым на сегодняшний день удалось исследовать лишь верхние слои вечной мерзлоты, а потому крайне сложно судить о том, какие открытия ожидают человечество в будущем.
Также Клаверье считает, что опасность спящих вирусов заключается именно в том, что современный человек никогда не контактировал с ними.
Но не только неизвестные вирусы, которые могут вновь появиться в современном мире, пугают исследователей. Клаверье упоминает вирус черной оспы, который терроризировал весь мир в прошлом, и который на сегодняшний день считается полностью истребленной болезнью. Вполне вероятно, что эта смертоносная инфекция все еще жива и хранится в недрах ледников, которые в скором времени выпустят ее снова, как это случилось в 2016 году на Ямале с вирусом сибирской язвы.
Экономическое освоение вечной мерзлоты
Современные ученые опасаются не только последствий глобального потепления, но и растущего интереса к освоению нетронутых территорий. Дело в том, что по мере изменений, происходящих под влиянием климатических катаклизмов, добыча минеральных ископаемых в зонах вечной мерзлоты становится возможной. Подобное вмешательство также грозит тем, что спящие вирусы вырвутся на свободу гораздо раньше, чем это произошло бы в естественных условиях, и никто не может предсказать последствия этих действий.
Заведующая лаборатории криологии почв Института физико-химических и биологических проблем почвоведения РАН Елизавета Ривкина считает, что эти территории представляют реальную угрозу для человечества, а потому к вопросу их освоения стоит подходить очень ответственно.
На данный момент вопрос с живущими во льдах вечной мерзлоты вирусами изучен не полностью, однако опасность определенно есть, и многие ученые выдвигают свои теории относительно того, что ожидает человечество в будущем и какие неприятные находки могут обнаружиться в этих зонах.
Некоторые из исследователей, отмечая возраст обнаруженных микроорганизмов, считают возможным сохранения в ледниках древних вирусов, которые стали причиной эпидемий и смертей древних людей – неандертальцев и денисовцев. Например, Саймон Андердаун из университета Брукс в Оксфорде считает, что возможная причина вымирания неандертальцев – губчатая энцефалопатия или коровье бешенство, которое поражало мозг заболевших. Археологи находили останки древних людей по всему миру, и нельзя исключать того факта, что и во льдах вечной мерзлоты заключены тела наших предков. А потому Андердаун считает вполне вероятным обнаружение древних вирусов на замерзших территориях.
Другие теории также связаны с доказанными случаями каннибализма у неандертальцев и денисовцев – древние люди совершали ритуальные убийства и часто употребляли в пищу мясо своих сородичей, что могло повлечь за собой массовые эпидемии и смерти.
Кроме того, исследователи однозначно уверены в существовании опасных вирусов прошлого в зонах вечной мерзлоты. Оспа, сибирская язва, чума – эти инфекционные заболевания унесли миллионы жизней как людей, так и животных, и их останки сегодня находятся в тающих льдах. Правда, относительно дальнейшего развития событий мнения ученых расходятся – одни исследователи считают, что предыдущий опыт поможет человечеству избежать массовых эпидемий после высвобождения вирусов, а другие склоняются к более пессимистичным прогнозам и допускают повторение пугающих событий прошлого.
Все это – лишь теории, которые пока не получили подтверждений. Однако уже существующие находки и реальные случаи воскрешения вируса изо льда заставляют поверить в то, что пугающие догадки ученых могут оказаться правдой, и вместе с таянием вечной мерзлоты в современном мире возродятся опаснейшие микроорганизмы, жившие во времена динозавров и мамонтов.
Пока весь мир думает, что делать с новым коронавирусом, еще одна важная новость осталась практически без должного внимания. Международная группа ученых, исследовавшая ледник в Тибете, опубликовала отчет о том, что в толще льда ею были обнаружены совершено новые вирусы, до сегодняшнего дня неизвестные науке. Подробнее – в колонке нашего обозревателя Николая Гринько.

Вирусологи изучали ледник на северо-западе Тибетского плато в Китае. Он образовывался в течение 15 000 лет, и за это время во льду были естественным образом законсервированы следы самых разных геологических эпох. Именно по этой причине историки, экологи, биологи и прочие ученые так любят исследовать ледники – ведь эти природные холодильники тысячелетиями хранят для них органику практически в неизменном виде.
Но если вам кажется, что поиски древних вирусов – дело нехитрое, то вы сильно ошибаетесь. Для того чтобы достать тысячелетний образец, необходимо пробурить лед специальным оборудованием на довольно большую глубину. Но беда в том, что абсолютно на всех инструментах, которыми приходится работать, есть современные вирусы и бактерии, которые здорово мешают проводить исследования: совершенно непонятно, содержались ли они внутри образца изначально или были занесены снаружи.
Пробы льда, с которыми работали вирусологи, были добыты довольно давно – в 1992 и 2015 годах. Их поверхность совершенно точно была "заселена" нынешними микроорганизмами и не годилась для исследований. Чтобы добыть "чистый лед", ученым пришлось потрудиться. Для начала они поместили образцы в камеру с температурой -5°C и сняли 5-миллиметровый слой льда ленточной пилой, которую предварительно пришлось тщательно стерилизовать. Затем лед обработали этанолом, растопив еще пять миллиметров, а после промыли дистиллированной водой – и снова минус полсантиметра. Только после этого можно было считать образцы более-менее очищенными.
Изучив образцы, ученые обнаружили вирусы 33 различных видов. Пять из них были уже известны науке (и не очень понятно, содержались ли они в пробах или были занесены снаружи), зато остальные 28 оказались совершенно новыми (точнее, очень старыми, существовавшими на Земле несколько тысячелетий назад).
Теперь о главном: чем все это нам грозит? На первый взгляд – ничем, ведь вирусы надежно законсервированы подо льдом последние 150 веков. Но климатологи давно бьют в набат, оповещая человечество о глобальном потеплении, и первая опасность, о которой они предупреждают, – таяние ледников. Теперь становится понятно, почему этот процесс может оказаться опасным. И дело не только в повышении уровня Мирового океана: растаявший тысячелетний лед выпустит на свободу органику, копившуюся в нем веками. Нет, динозавры наружу не полезут, и вообще жизнь в таких условиях не сохраняется. Но вот вирусы. Ученые до сих пор не могут определиться – относить ли вирусы к живой или же к неживой природе. И одним из их свойств как раз является способность сохраняться в течение долгого времени. Теоретически – неограниченного.

Древние вирусы, вышедшие в современную биосферу, могут наделать немало бед. Нынешние организмы давно утратили к ним иммунитет, что может вызвать серьезные проблемы. Но с другой стороны, современные условия – температура, состав атмосферы, уровень солнечной радиации – могут оказаться для них губительными, и тогда вообще ничего не произойдет.
Строго говоря, ученые пока не знают, опасны ли вирусы возрастом 15 тысяч лет. Именно на этот вопрос они и пытаются ответить, изучая все полученные образцы. И если в конце концов ледники растают и вирусы выберутся на свободу, мы хотя бы будем к этому готовы: разработаем способы защиты, лекарства и так далее.
Между прочим, тибетский ледник – это далеко не самое старое скопление льда на планете. По геологическим меркам возраст в 150 веков просто смешон. Вот, скажем, ледяному щиту Антарктиды примерно 45 миллионов лет. Только представьте, сколько бактерий, вирусов и прочей органики в нем содержится! Очень хочется верить, что этот лед еще долго не растает.


За последние несколько столетий человечество сделало несколько огромных шагов вперед – люди изобрели Интернет, научились лечить болезни, которые ранее считались смертельными, создали искусственный интеллект и даже побывали в космосе. Тем не менее, огромное количество природных явлений все еще остается загадкой для человека.
Сегодня весь мир отчаянно борется с коронавирусом, который стремительно распространяется по нашей планете, и подобные эпидемии случаются регулярно – вирус Эбола и Марбурга, вспышки свиного и птичьего гриппа, атипичная пневмония, желтая лихорадка. И в этот список входят только те пандемии, которые случились на Земле за последние десять лет.


И все же, все вышеперечисленные вирусы уже были известны науке, поскольку являлись мутировавшими версиями существующих. Однако наша планета хранит куда более загадочные и пугающие находки, которые могут воскреснуть спустя тысячи и даже миллионы лет сна.


Еще в 1979 году советский доктор биологических наук Сабит Абызов изучал ледники в Антарктиде и сделал удивительное открытие. В замершем грунте он обнаружил живые микроорганизмы, которым было более 400 тысяч лет. Эта находка вдохновила ученых со всего мира продолжить поиски древних организмов в ледниках – и их исследования вскоре дали свои плоды.
Уже в 2007 году исследователям из Копенгагенского университета удалось выделить ДНК из бактерий, чей возраст достигал примерно полумиллиона лет, а спустя несколько лет ученый из России обнаружил еще более древние микроорганизмы, возрастом около 3,5 миллионов лет. Самой древней находкой стали соляные кристаллы из США с живыми бактериями, которые застали зарождение динозавров на нашей планете.
Найденные микроорганизмы, мимивирусы, пандоравирусы, питовирусы и молливирусы, получили название гигантских вирусов, поскольку их размер составляет около одного микрометра и его даже можно увидеть в обычный оптический микроскоп.


Эти типы вирусов не несут прямой угрозы человечеству, поскольку имеют способность паразитировать лишь на амебах. Однако никто с точностью не может сказать, какие еще микроорганизмы сохранились во льдах вечной мерзлоты, и какое влияние они могут оказать на людей в случае активации, а тот факт, что жизнь в вечной мерзлоте существует, и существует уже на протяжении стольких лет, говорит о том, что наша планета действительно изучена не до конца и хранит массу загадок.
В 2016 году группа исследователей обнаружила под землей пещер в Нью-Мексико особый вид бактерий Paenibacillus, которые жили еще четыре миллиона лет тому назад. Проведя ряд исследований, ученые выяснили, что найденные микроорганизмы устойчивы к 70% современных антибиотиков. Это исследование поразило биологов – бактерии, которые провели столько времени в ледяном заточении без возможности размножаться, адаптировались к условиям и смогли выжить, при этом выработав иммунитет к большинству современных лекарств.


А чуть позже, в том же 2016 году, мир столкнулся с реальной эпидемией, начавшейся после таяния льдов. Четыре года назад в Салехарде была зафиксирована вспышка сибирской язвы – это произошло впервые за последние 75 лет, а причиной эпидемии стали микроорганизмы, жившие в замерзших могильниках.
Дело в том, что в период с 1897 по 1925 года на территориях Ямала были захоронены сотни погибших от сибирской язвы оленей, после чего эти захоронения стали частью замерзших территорий. Однако летом 2016 года в Ямало-Ненецком округе были зафиксированы рекордно высокие температуры, и ледники начали таять, освобождая смертоносные бактерии.


В результате эпидемии погибло почти три тысячи оленей, девяносто человек попали в инфекционные больницы и один ребенок скончался.
Этот инцидент обеспокоил исследователей, поскольку во льдах вечной мерзлоты находится масса трупов животных, которые погибали от давно забытых вирусных инфекций, а также старые кладбища и тела тех людей, которые умерли в результате чумы, оспы, холеры и других опаснейших заболеваний прошлого.
Кроме того, все новые и новые открытия исследователей говорят о том, что в толще льда могут находиться и более опасные и разнообразные вирусы, которые способны вызывать целые эпидемии. Открыватель одного из гигантских вирусов Жан-Мишель Клаверье считает, что эти опасения не напрасны – таяние льдов началось еще в 1970 году, и нет оснований полагать, что этот процесс завершится. Одновременно с этим ученым на сегодняшний день удалось исследовать лишь верхние слои вечной мерзлоты, а потому крайне сложно судить о том, какие открытия ожидают человечество в будущем.
Также Клаверье считает, что опасность спящих вирусов заключается именно в том, что современный человек никогда не контактировал с ними.
Но не только неизвестные вирусы, которые могут вновь появиться в современном мире, пугают исследователей. Клаверье упоминает вирус черной оспы, который терроризировал весь мир в прошлом, и который на сегодняшний день считается полностью истребленной болезнью. Вполне вероятно, что эта смертоносная инфекция все еще жива и хранится в недрах ледников, которые в скором времени выпустят ее снова, как это случилось в 2016 году на Ямале с вирусом сибирской язвы.
Современные ученые опасаются не только последствий глобального потепления, но и растущего интереса к освоению нетронутых территорий. Дело в том, что по мере изменений, происходящих под влиянием климатических катаклизмов, добыча минеральных ископаемых в зонах вечной мерзлоты становится возможной. Подобное вмешательство также грозит тем, что спящие вирусы вырвутся на свободу гораздо раньше, чем это произошло бы в естественных условиях, и никто не может предсказать последствия этих действий.


Заведующая лаборатории криологии почв Института физико-химических и биологических проблем почвоведения РАН Елизавета Ривкина считает, что эти территории представляют реальную угрозу для человечества, а потому к вопросу их освоения стоит подходить очень ответственно.


На данный момент вопрос с живущими во льдах вечной мерзлоты вирусами изучен не полностью, однако опасность определенно есть, и многие ученые выдвигают свои теории относительно того, что ожидает человечество в будущем и какие неприятные находки могут обнаружиться в этих зонах.


Некоторые из исследователей, отмечая возраст обнаруженных микроорганизмов, считают возможным сохранения в ледниках древних вирусов, которые стали причиной эпидемий и смертей древних людей – неандертальцев и денисовцев. Например, Саймон Андердаун из университета Брукс в Оксфорде считает, что возможная причина вымирания неандертальцев – губчатая энцефалопатия или коровье бешенство, которое поражало мозг заболевших. Археологи находили останки древних людей по всему миру, и нельзя исключать того факта, что и во льдах вечной мерзлоты заключены тела наших предков. А потому Андердаун считает вполне вероятным обнаружение древних вирусов на замерзших территориях.
Другие теории также связаны с доказанными случаями каннибализма у неандертальцев и денисовцев – древние люди совершали ритуальные убийства и часто употребляли в пищу мясо своих сородичей, что могло повлечь за собой массовые эпидемии и смерти.


Кроме того, исследователи однозначно уверены в существовании опасных вирусов прошлого в зонах вечной мерзлоты. Оспа, сибирская язва, чума – эти инфекционные заболевания унесли миллионы жизней как людей, так и животных, и их останки сегодня находятся в тающих льдах. Правда, относительно дальнейшего развития событий мнения ученых расходятся – одни исследователи считают, что предыдущий опыт поможет человечеству избежать массовых эпидемий после высвобождения вирусов, а другие склоняются к более пессимистичным прогнозам и допускают повторение пугающих событий прошлого.
Все это – лишь теории, которые пока не получили подтверждений. Однако уже существующие находки и реальные случаи воскрешения вируса изо льда заставляют поверить в то, что пугающие догадки ученых могут оказаться правдой, и вместе с таянием вечной мерзлоты в современном мире возродятся опаснейшие микроорганизмы, жившие во времена динозавров и мамонтов.
На протяжении истории нашей планеты люди сосуществовали с бактериями и вирусами. Мы искали способы противостоять бубонной чуме и оспе, а они в ответ искали способы нас заражать. Вот уже почти сто лет мы пользуемся антибиотиками, с тех пор как Александр Флеминг открыл пенициллин. В ответ на это бактерии обзавелись устойчивостью к антибиотикам. Битве нет конца. Мы проводим так много времени с патогенами, что по очереди заводим друг друга в тупик. Однако что произойдет, если мы внезапно столкнемся со смертельными бактериями и вирусами, которых не встречали уже тысячи лет либо не видели никогда?

Опасный вирус можно обнаружить даже в леднике
Возможно, мы скоро это узнаем. Изменения климата выливаются таянием вечномерзлых почв, которые были заморожены в течение тысяч лет, и по мере таяния почв выходят древние вирусы и бактерии, которые оживают и возвращаются к жизнедеятельности.
В августе 2016 года в далеком уголке сибирской тундры, на полуострове Ямал, умер 12-летний мальчик и не менее двадцати человек были госпитализированы после заражения сибирской язвой.
Было выдвинуто предположение, что более 75 лет назад олень, зараженный сибирской язвой, умер и его замороженный скелет оказался в ловушке под слоем мерзлой почвы, под вечной мерзлотой. Там он оставался до лета 2016 года, когда из-за сильной жары вечная мерзлота оттаяла. Тем самым выпустила труп оленя и инфекцию сибирской язвы в ближайшие воды и почвы, а после и в продовольственный запас. Люди оказались под угрозой.
Страшно то, что это может быть не одиночный случай.
Откуда берутся вирусы

Сибирская язва не зря так называется
Земля нагревается и оттаивает больше вечной мерзлоты. При нормальных условиях поверхностные слои вечной мерзлоты глубиной около 50 сантиметров подтаивают каждое лето. Но глобальное потепление постепенно обнажает старые слои мерзлоты.
Замерзшая многолетняя почва — идеальное место для того, чтобы бактерии оставались живыми в течение длительных периодов времени, возможно, миллионы лет. Это означает, что тающий лед потенциально может открыть ящик Пандоры с болезнями.
Температура в полярном круге быстро растет, примерно в три раза быстрее, чем в остальном мире. Наружу могут выйти и другие инфекционные агенты.
Только в начале 20 века более миллиона северных оленей погибли от сибирской язвы. На севере не так-то просто выкопать глубокие могилы, поэтому большинство этих туш похоронили близко к поверхности, в 7000 разбросанных захоронениях на севере России.
Что находится под ледниками

Под мерзлой почвой можно обнаружить удивительные находки
В 1890-х годах в Сибири прошла серьезная эпидемия оспы. Один город потерял до 40% своего населения. Тела были захоронены под верхним слоем вечной мерзлоты на берегу реки Колымы. Через 120 лет наводнения Колымы начали разрушать берега, и таяние вечной мерзлоты ускорило этот процесс эрозии.
В проекте, который начался в 1990-х годах, ученые из Государственного научного центра вирусологии и биотехнологии в Новосибирске изучили остатки людей каменного века, обнаруженных в южной Сибири, в районе Горного Алтая. Они также изучили образцы из трупов людей, которые умерли во время вирусных эпидемий в 19 веке и были захоронены в вечной мерзлоте России.
Ученые говорят, что нашли тела с язвами, характерными для следов оспы. Хотя они и не обнаружили сам вирус оспы, они обнаружили фрагменты ДНК.
Конечно, это не первый случай, когда бактерии, замороженные во льду, снова оживают.
В исследовании 2005 года ученые NASA успешно возродили бактерии, заключенные в замороженном пруду на Аляске в течение 32 000 лет. Микробы под названием Carnobacterium pleistocenum были заморожены со времен плейстоцена, когда шерстяные мамонты все еще бродили по Земле. Как только лед растаял, они снова начали плавать как ни в чем не бывало.
Два года спустя ученым удалось возродить бактерию возрастом 8 миллионов лет, которая спала во льду под поверхностью ледника в долинах Бикон и Маллинз в Антарктиде. В то же исследовании бактерий восстановили из льда, которому было более 100 000 лет.
Однако не все бактерии могут вернуться к жизни после замораживания в вечной мерзлоте. Бактерии сибирской язвы могут это сделать, потому что образуют чрезвычайно выносливые споры, которые могут жить в замороженном состоянии очень долго.
Другие бактерии, которые могут образовывать споры, а значит и выживать в вечной мерзлоте, включают столбняк и Clostridium botulinum, ответственную за ботулизм: редкое заболевание, которое может вызвать паралич и привести к смерти. Некоторые грибы также могут выжить в вечной мерзлоте в течение длительного времени.
Чем болели люди
Некоторые вирусы также могут выживать в течение длительных периодов времени.
Сразу после возрождения вирусы стали заразными. К счастью для нас, конкретно эти вирусы заражают только одноклеточные амебы. Тем не менее исследование предполагает, что другие вирусы, которые могут заражать людей, тоже могут быть возрождены.
Более того, глобальное потепление необязательно должно плавить вечные мерзлоты, чтобы представлять угрозу. Поскольку арктический морской лед тает, северный берег Сибири становится легче достичь по морю. Очевидно, становится более выгодным промышленное его освоение, включая добычу золота и минералов, бурение нефтяных скважин, добыча природного газа.
Гигантские вирусы могут стать наиболее вероятными виновниками вирусной вспышки.

Так под микроскопом выглядит Bacillus cereus
Клавери говорит, что могут проявиться вирусы от самых первых людей, населявших Арктику. Мы могли бы даже увидеть вирусы давно вымерших видов гоминид вроде неандертальцев и денисовцев, которые обосновались в Сибири и подвергались воздействию различных вирусных заболеваний. В России находили останки неандертальцев возрастом 30-40 000 лет. Популяции людей жили там, болели и умирали тысячи лет.
С 2014 года Клавери анализирует содержание ДНК в многолетней мерзлоте в поисках генетической сигнатуры вирусов и бактерий, которые могут инфицировать людей. Он нашел множество бактерий, которые могут быть опасны для людей. У бактерий есть ДНК, которая кодирует факторы вирулентности: молекул, которые производят патогенные бактерии и вирусы, которые увеличивают их способность заражать хозяина.
Команда Клавери также обнаружила несколько последовательностей ДНК, которые, кажется, взялись от вирусов, включающих герпес. Но следов оспы пока не нашли. По очевидным причинам они не пытались возродить какой-либо из патогенов.
Вполне может быть, что патогены, от которых уже отвыкли люди, могут проявиться и в других местах, а не только из льда или вечной мерзлоты.
Микробы и бактерии — в чем разница?
В феврале 2017 года ученые NASA заявили, что нашли микробов возрастом 10-50 000 лет в кристаллах в мексиканской шахте. Эти бактерии были расположены в Пещере Кристаллов, части шахты в Найце в северной Мексике. Пещера содержит много молочно-белых кристаллов минерального селенита, который образовался за сотни тысяч лет.
Бактерии были заперты в маленьких, жидких карманах кристаллов, но как только их вытащили, они возродились и начали размножаться. Эти микробы генетически уникальны и вполне могут быть новыми видами, но ученые пока не опубликовали свою работу.

Некоторые бактерии живут тысячи лет
В пещере Лечугилья в Нью-Мексико, в 300 метрах под землей нашли еще более старых бактерий. Эти микробы не видели поверхности более 4 миллионов лет. Пещера никогда не видела солнечного света и была изолирована в течение 10 000 лет от поверхностных вод.
Поскольку бактерии оказались полностью изолированы в пещере в течение четырех миллионов лет, они не вступали в контакт с людьми или антибиотиками, которыми мы лечим инфекции. Выходит, их устойчивость к антибиотикам появилась как-то иначе.
Ученые считают, что бактерии, которые не наносят вред людям, среди многих других вырабатывают естественную устойчивость к антибиотикам. То есть эта самая устойчивость к антибиотикам существует в течение миллионов или даже миллиардов лет.
Очевидно, такая антибиотикорезистентность не могла развиться в клинике в процессе использования антибиотиков.
Причиной этого является то, что многие виды грибов и даже другие бактерии естественным образом производят антибиотики, чтобы получить конкурентное преимущество перед другими микробами. Именно так Флеминг впервые обнаружил пенициллин: бактерии в чашке Петри умерли после загрязнения вырабатывающими антибиотики плесневыми грибами.
В пещерах, где мало еды, организмы должны быть безжалостными, если хотят выжить. Бактерии вроде Paenibacillus, возможно, должны были развить устойчивость к антибиотикам, чтобы избежать смерти от конкурирующих организмов.
Это объясняет, почему бактерии устойчивы только к естественным антибиотикам, которые поступают от бактерий и грибов, и составляют около 99,9% всех используемых нами антибиотиков. Бактерии никогда не сталкивались с искусственными антибиотиками, поэтому не имеют к ним сопротивления.

Первые многоклеточные организмы
Хотя Paenibacillis не вреден для человека, в теории он может передать свою антибиотикорезистентность другим патогенам. Но поскольку он изолирован под 400 метрами пород, это кажется маловероятным.
Тем не менее природная антибиотикорезистентность к антибиотикам, вероятно, так распространена, что многие из бактерий, выходящих из тающей вечной мерзлоты, могут уже ею обладать. В подтверждение этого в исследовании 2011 года ученые извлекли ДНК из бактерий, обнаруженных в вечной мерзлоте возрастом 30 000 лет в Беринговом море. Они нашли гены, кодирующие устойчивость к бета-лактамным, тетрациклиновым и гликопептидным антибиотикам.
Опасность микробов для человека
Еще есть мнение, что не стоит игнорировать риски, когда мы не можем их количественно оценить.
Читайте также:


